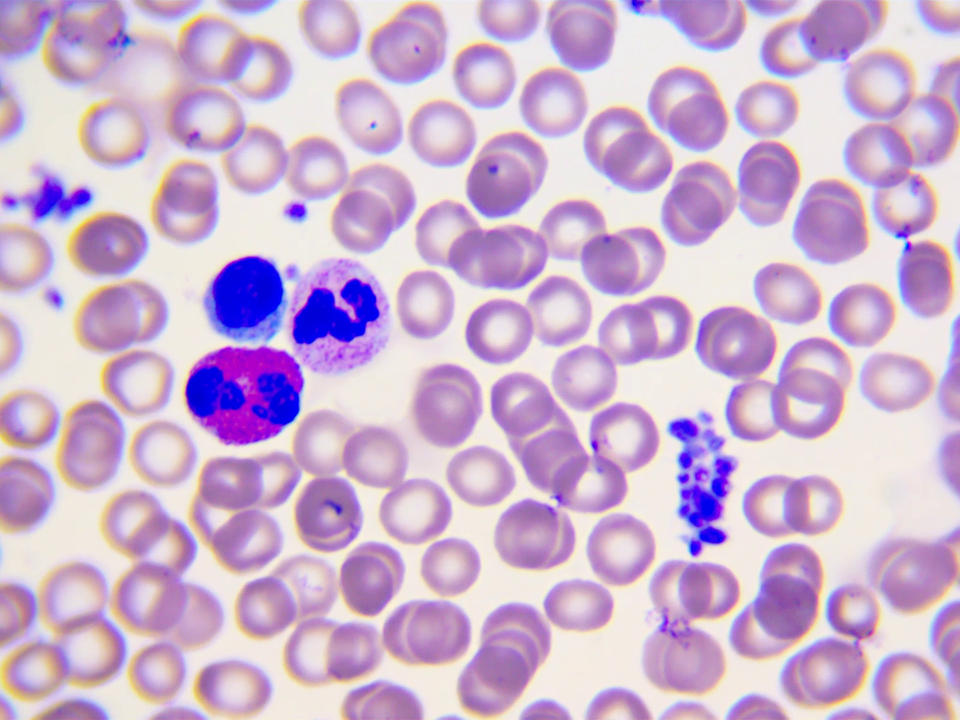

Symulacja interaktywna II
Wirtualny mikroskop
Za pomocą wirtualnego mikroskopu przeprowadź obserwację elementów morfotycznych krwi. Zwróć uwagę na kształt i rozmiar jądra komórkowego oraz wybarwienie ziarnistości w komórkach leukocytów, które są widoczne w rozmazie.
Za pomocą wirtualnego mikroskopu przeprowadzono obserwację elementów morfotycznych krwi. Pod mikroskopem w rozmazie krwi są widoczne erytrocyty z przejaśnieniami w środku, które zdecydowanie dominują liczebnie. Możesz jednak również dostrzec liczne leukocyty. W symulacji początkowo w obrazie mikroskopowym widać zagęszczenie różowych kropek (powiększenie 10 x). W zbliżeniu czterdziestokrotnym widoczne są te same struktury, ale ich kształt jest okrągły lub owalny, a kolor jasnoróżowy. Niekiedy znajdują się one w skupiskach po 2‑3. Pomiędzy nimi rzadko występują fioletowe struktury. W zbliżeniu stukrotnym kropki są jasnoróżowe, a ich środki jasne. Pomiędzy nimi rzadko występują fioletowe struktury.
Szczegóły obserwacji mikroskopowej. W powiększeniu tysiąckrotnym pomiędzy gęsto rozlokowanymi jasnoróżowymi okrągłymi i owalnymi elementami z jasnymi środkami są struktury, czasem bezkształtne, wybarwione na kolor fioletowy.

Film dostępny pod adresem /preview/resource/RaqQ7XxTDcIW7
Film nawiązujący do treści materiału, zawiera wskazówki dotyczące sposobu używania mikroskopu, jak i przykłady obserwacji.
Ogólne wskazówki dotyczące techniki mikroskopowania w warunkach szkolnych.
1. Należy ustawić właściwe oświetlenie pola widzenia (tak aby uzyskać równomierne, jasne oświetlenie). 2. Preparat umieszcza się na stoliku przedmiotowym między łapkami mikroskopu. 3. Za pomocą śrub służących do przesuwania preparatu ustawia się obiekt obserwacji mniej więcej na przedłużeniu osi obiektywu. 4. Najpierw wybiera się obiektyw o najmniejszym powiększeniu. 5. Patrząc przez okular, należy podnosić stolik przedmiotowy, aż do uzyskania obrazu. 6. Obraz wyostrza się za pomocą śruby mikrometrycznej. Można wówczas skorygować światło. 7. Aby zmienić powiększenie, należy przekręcić rewolwer na obiektyw o większym powiększeniu, np. 10×, 40×. 8. Ostrość obrazu koryguje się za pomocą śruby mikrometrycznej. 9. Po ukończeniu obserwacji należy opuścić stolik i wyłączyć światło, a następnie wyjąć preparat i ustawić obiektyw o najmniejszym powiększeniu: 4×. 10. Mikroskop przykrywa się foliowym pokrowcem, aby uchronić go przed zabrudzeniami.
Przeprowadzając obserwację mikroskopową za pomocą wirtualnego mikroskopu, odszukaj na preparacie: neutrofil, eozynofil, limfocyt i monocyt.
Podpisz leukocyty (krwinki białe).
Przeprowadzając obserwację za pomocą wirtualnego mikroskopu, ustaw tak pole widzenia, aby można było dokładnie przyjrzeć się neutrofilowi, a następnie odpowiedz na poniższe pytania.